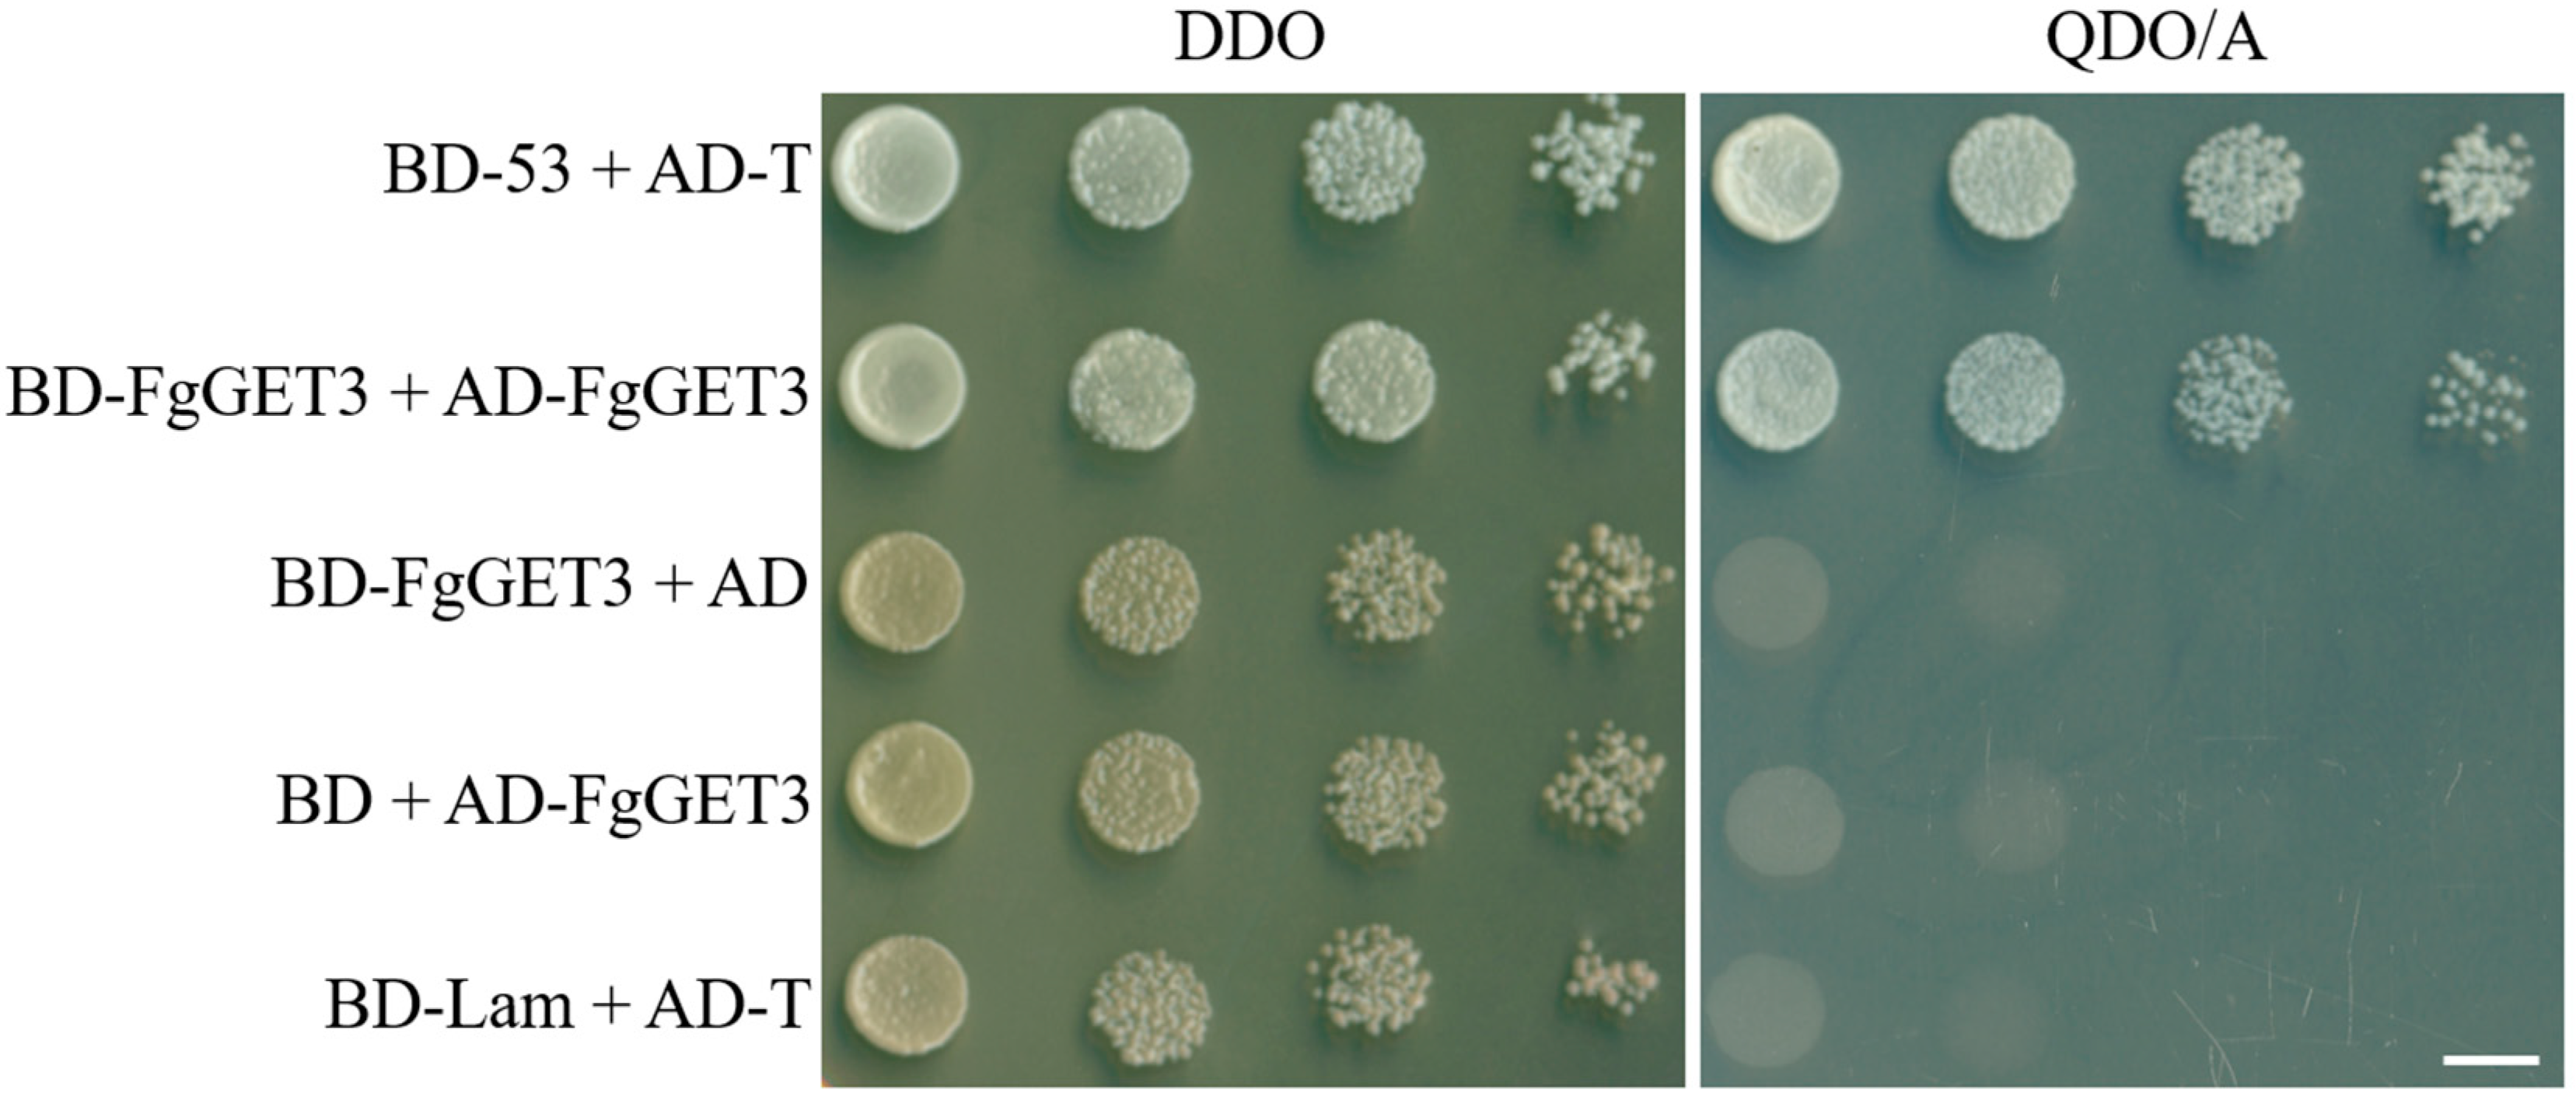
Ijms 25 12172 g003

FgGET3, an ATPase of the GET Pathway, Is Important for the Development and Virulence of Fusarium graminearum
Abstract
1. Introduction
2. Results
2.1. Identification of FgGET3 in F. graminearum
2.2. FgGET3 Restores the Growth Defect of the Yeast ScGET3 KO Mutant
2.3. FgGET3 Forms a Homodimer
2.4. FgGET3 Localizes in the Cytoplasm
2.5. Generation of FgGET3 Mutants
2.6. FgGET3 Is Involved in Hyphal Growth and Vacuole Fusion
2.7. FgGET3 Is Involved in Fungal Responses to Various Stresses
2.8. FgGET3 Plays a Critical Role in Asexual Development
2.9. FgGET3 Is Required for Virulence and DON Production
3. Discussion
4. Materials and Methods
4.1. Fungal Strains and Growth Conditions
4.2. Sequence Analysis
4.3. Fungal Transformation
4.4. Virulence and DON Production Assays
4.5. Nucleic Acid Extraction and PCR Assay
4.6. Staining and Microscopic Examination
4.7. Yeast Complementation Assay
4.8. Yeast Two-Hybrid Assay
4.9. Statistical Analyses
5. Conclusions
Supplementary Materials
Author Contributions
Funding
Institutional Review Board Statement
Informed Consent Statement
Data Availability Statement
Conflicts of Interest
References
- Kutay, U.; Hartmann, E.; Rapoport, T.A. A class of membrane proteins with a C-terminal anchor. Trends Cell Biol. 1993, 3, 72–75. [Google Scholar] [CrossRef] [PubMed]
- Hegde, R.S.; Keenan, R.J. Tail-anchored membrane protein insertion into the endoplasmic reticulum. Nat. Rev. Mol. Cell Biol. 2011, 12, 787–798. [Google Scholar] [CrossRef] [PubMed]
- Chartron, J.W.; Clemons, W.M.; Suloway, C.J.M. The complex process of GETting tail-anchored membrane proteins to the ER. Curr. Opin. Struct. Biol. 2012, 22, 217–224. [Google Scholar] [CrossRef] [PubMed]
- Mateja, A.; Keenan, R.J. A structural perspective on tail-anchored protein biogenesis by the GET pathway. Curr. Opin. Struct. Biol. 2018, 51, 195–202. [Google Scholar] [CrossRef]
- Schuldiner, M.; Metz, J.; Schmid, V.; Denic, V.; Rakwalska, M.; Schmitt, H.D.; Schwappach, B.; Weissman, J.S. The GET complex mediates insertion of tail-anchored proteins into the ER membrane. Cell 2008, 134, 634–645. [Google Scholar] [CrossRef]
- Wang, F.; Whynot, A.; Tung, M.; Denic, V. The mechanism of tail-anchored protein insertion into the ER membrane. Mol. Cell. 2011, 43, 738–750. [Google Scholar] [CrossRef]
- Simpson, P.J.; Schwappach, B.; Dohlman, H.G.; Isaacson, R.L. Structures of get3, get4, and get5 provide new models for TA membrane protein targeting. Structure 2010, 18, 897–902. [Google Scholar] [CrossRef]
- Shen, J.; Hsu, C.M.; Kang, B.K.; Rosen, B.P.; Bhattacharjee, H. The Saccharomyces cerevisiae Arr4p is involved in metal and heat tolerance. Biometals 2003, 16, 369–378. [Google Scholar] [CrossRef]
- Voth, W.; Schick, M.; Gates, S.; Li, S.; Vilardi, F.; Gostimskaya, I.; Southworth, D.R.; Schwappach, B.; Jakob, U. The protein targeting factor Get3 functions as ATP-independent chaperone under oxidative stress conditions. Mol. Cell 2014, 56, 116–127. [Google Scholar] [CrossRef]
- Xing, S.; Mehlhorn, D.G.; Wallmeroth, N.; Asseck, L.Y.; Kar, R.; Voss, A.; Denninger, P.; Schmidt, V.A.F.; Schwarzländer, M.; Stierhof, Y.D.; et al. Loss of GET pathway orthologs in Arabidopsis thaliana causes root hair growth defects and affects SNARE abundance. Proc. Natl. Acad. Sci. USA 2017, 114, e1544–e1553. [Google Scholar] [CrossRef]
- Srivastava, R.; Zalisko, B.E.; Keenan, R.J.; Howell, S.H. The GET system inserts the tail-anchored protein, SYP72, into endoplasmic reticulum membranes. Plant Physiol. 2017, 173, 1137–1145. [Google Scholar] [CrossRef] [PubMed]
- Mukhopadhyay, R.; Ho, Y.S.; Swiatek, P.J.; Rosen, B.P.; Bhattacharjee, H. Targeted disruption of the mouse Asna1 gene results in embryonic lethality. Febs Letters 2006, 580, 3889–3894. [Google Scholar] [CrossRef] [PubMed]
- Kumar, T.; Maitra, S.; Rahman, A.; Bhattacharjee, S. A conserved guided entry of tail-anchored pathway is involved in the trafficking of a subset of membrane proteins in Plasmodium falciparum. PLoS Pathog. 2021, 17, e1009595. [Google Scholar] [CrossRef] [PubMed]
- Dean, R.; Van Kan, J.A.L.; Pretorius, Z.A.; Hammond-Kosack, K.E.; Di Pietro, A.; Spanu, P.D.; Rudd, J.J.; Dickman, M.; Kahmann, R.; Ellis, J.; et al. The top 10 fungal pathogens in molecular plant pathology. Mol. Plant Pathol. 2012, 13, 414–430. [Google Scholar] [CrossRef]
- Figueroa, M.; Hammond-Kosack, K.E.; Solomon, P.S. A review of wheat diseases-a field perspective. Mol. Plant Pathol. 2018, 19, 1523–1536. [Google Scholar] [CrossRef]
- Powell, A.J.; Vujanovic, V. Evolution of Fusarium head blight management in wheat: Scientific perspectives on biological control agents and crop genotypes protocooperation. Appl. Sci. 2021, 11, 8960. [Google Scholar] [CrossRef]
- Van Egmond, H.P.; Schothorst, R.C.; Jonker, M.A. Regulations relating to mycotoxins in food: Perspectives in a global and European context. Anal. Bioanal. Chem. 2007, 389, 147–157. [Google Scholar] [CrossRef]
- Trail, F. For Blighted Waves of Grain: Fusarium graminearum in the postgenomics era. Plant Physiol. 2009, 149, 103–110. [Google Scholar] [CrossRef]
- Kazan, K.; Gardiner, D.M.; Manners, J.M. On the trail of a cereal killer: Recent advances in Fusarium graminearum pathogenomics and host resistance. Mol. Plant Pathol. 2012, 13, 399–413. [Google Scholar] [CrossRef]
- Chen, A.H.; Islam, T.; Ma, Z.H. An integrated pest management program for managing Fusarium head blight disease in cereals. J. Integr. Agric. 2022, 21, 3434–3444. [Google Scholar] [CrossRef]
- Niu, G.; Yang, Q.; Liao, Y.; Sun, D.; Tang, Z.; Wang, G.; Xu, M.; Wang, C.W.; Kang, J.G. Advances in understanding Fusarium graminearum: Genes involved in the regulation of sexual development, pathogenesis, and deoxynivalenol biosynthesis. Genes 2024, 15, 475. [Google Scholar] [CrossRef] [PubMed]
- Xu, M.; Wang, Q.; Wang, G.; Zhang, X.; Liu, H.; Jiang, C. Combatting Fusarium head blight: Advances in molecular interactions between Fusarium graminearum and wheat. Phytopathol. Res. 2022, 4, 37. [Google Scholar] [CrossRef]
- Rampersad, S.N. Pathogenomics and management of Fusarium diseases in plants. Pathogens 2020, 9, 340. [Google Scholar] [CrossRef] [PubMed]
- Leipe, D.D.; Wolf, Y.I.; Koonin, E.V.; Aravind, L. Classification and evolution of P-loop GTPases and related ATPases. J. Mol. Biol. 2002, 317, 41–72. [Google Scholar] [CrossRef]
- Mariappan, M.; Mateja, A.; Dobosz, M.; Bove, E.; Hegde, R.S.; Keenan, R.J. The mechanism of membrane-associated steps in tail-anchored protein insertion. Nature 2011, 477, 61–69. [Google Scholar] [CrossRef]
- Stefer, S.; Reitz, S.; Wang, F.; Wild, K.; Pang, Y.Y.; Schwarz, D.; Bomke, J.; Hein, C.; Löhr, F.; Bernhard, F.; et al. Structural basis for tail-anchored membrane protein biogenesis by the Get3-receptor complex. Science 2011, 333, 758–762. [Google Scholar] [CrossRef]
- Mateja, A.; Szlachcic, A.; Downing, M.E.; Dobosz, M.; Mariappan, M.; Hegde, R.S.; Keenan, R.J. The structural basis of tail-anchored membrane protein recognition by Get3. Nature 2009, 461, 361–366. [Google Scholar] [CrossRef]
- Gristick, H.B.; Rao, M.; Chartron, J.W.; Rome, M.E.; Shan, S.O.; Clemons, W.M. Crystal structure of ATP-bound Get3-Get4-Get5 complex reveals regulation of Get3 by Get4. Nat. Struct. Mol. Biol. 2014, 21, 437–442. [Google Scholar] [CrossRef]
- Boenisch, S.; Boenisch, M.J.; Schäfer, W. Fusarium graminearum forms mycotoxin producing infection structures on wheat. BMC Plant Biol. 2011, 11, 110. [Google Scholar] [CrossRef]
- Mateja, A.; Paduch, M.; Chang, H.Y.; Szydlowska, A.; Kossiakoff, A.A.; Hegde, R.S.; Keenan, R.J. Structure of the Get3 targeting factor in complex with its membrane protein cargo. Science 2015, 347, 1152–1155. [Google Scholar] [CrossRef]
- Brown, J.A.; Sherlock, G.; Myers, C.L.; Burrows, N.M.; Deng, C.; Wu, H.I.; McCann, K.E.; Troyanskaya, O.G.; Brown, J.M. Global analysis of gene function in yeast by quantitative phenotypic profiling. Mol. Syst. Biol. 2006, 2, 2006.0001. [Google Scholar] [CrossRef] [PubMed]
- Jiang, C.; Zhang, C.; Wu, C.; Sun, P.; Hou, R.; Liu, H.; Wang, C.; Xu, J.R. TRI6 and TRI10 play different roles in the regulation of deoxynivalenol (DON) production by CAMP signaling in Fusarium graminearum. Environ. Microbiol. 2016, 18, 3689–3701. [Google Scholar] [CrossRef] [PubMed]
- Chen, Y.; Kistler, H.C.; Ma, Z. Annual review of phytopathology Fusarium graminearum trichothecene mycotoxins: Biosynthesis, regulation, and management. Annu. Rev. Phytopathol. 2019, 57, 15–39. [Google Scholar] [CrossRef]
- Qi, P.F.; Zhang, Y.Z.; Liu, C.H.; Zhu, J.; Chen, Q.; Guo, Z.R.; Wang, Y.; Xu, B.J.; Zheng, T.; Jiang, Y.F.; et al. Fusarium graminearum ATP-binding cassette transporter gene FgABCC9 is required for its transportation of salicylic acid, fungicide resistance, mycelial growth and pathogenicity towards wheat. Int. J. Mol. Sci. 2018, 19, 2351. [Google Scholar] [CrossRef]
- Qi, P.F.; Johnston, A.; Balcerzak, M.; Rocheleau, H.; Harris, L.J.; Long, X.Y.; Wei, Y.M.; Zheng, Y.L.; Ouellet, T. Effect of salicylic acid on Fusarium graminearum, the major causal agent of fusarium head blight in wheat. Fungal Biol. 2012, 116, 413–426. [Google Scholar] [CrossRef]
- Yun, Y.; Liu, Z.; Yin, Y.; Jiang, J.; Chen, Y.; Xu, J.R.; Ma, Z. Functional analysis of the Fusarium graminearum phosphatome. New Phytol. 2015, 207, 119–134. [Google Scholar] [CrossRef]
- Hou, Z.; Xue, C.; Peng, Y.; Katan, T.; Corby Kistler, H.; Xu, J.R. A mitogen-activated protein kinase gene (MGV1) in Fusarium graminearum is required for female fertility, heterokaryon formation, and plant infection. Mol. Plant Microbe Interact. 2002, 15, 1119–1127. [Google Scholar] [CrossRef]
- Frandsen, R.J.N.; Andersson, J.A.; Kristensen, M.B.; Giese, H. Efficient four fragment cloning for the construction of vectors for targeted gene replacement in filamentous fungi. BMC Mol. Biol. 2008, 9, 70. [Google Scholar] [CrossRef]
- Michielse, C.B.; Hooykaas, P.J.J.; van den Hondel, C.A.M.J.J.; Ram, A.F.J. Agrobacterium-mediated transformation as a tool for functional genomics in fungi. Curr. Genet. 2005, 48, 1–17. [Google Scholar] [CrossRef]
- Catlett, N.L.; Lee, B.N.; Yoder, O.C.; Turgeon, B.G. Split-marker recombination for efficient targeted deletion of fungal genes. Fungal Genet. Rep. 2003, 50, 9–11. [Google Scholar] [CrossRef]
- Crespo-Sempere, A.; López-Pérez, M.; Martínez-Culebras, P.V.; González-Candelas, L. Development of a green fluorescent tagged strain of Aspergillus Carbonarius to monitor fungal colonization in grapes. Int. J. Food Microbiol. 2011, 148, 135–140. [Google Scholar] [CrossRef] [PubMed]
- Chen, Q.; Lei, L.; Liu, C.H.; Zhang, Y.Z.; Xu, Q.; Zhu, J.; Guo, Z.; Wang, Y.; Li, Q.C.; Li, Y.; et al. Major facilitator superfamily transporter gene FgMFS1 is essential for Fusarium graminearum to deal with salicylic acid stress and for its pathogenicity towards wheat. Int. J. Mol. Sci. 2021, 22, 8497. [Google Scholar] [CrossRef] [PubMed]
- Livak, K.J.; Schmittgen, T.D. Analysis of relative gene expression data using real-time quantitative PCR and the 2(-Delta Delta C(T)) Method. Methods 2001, 25, 402–408. [Google Scholar] [CrossRef] [PubMed]
- Shoji, J.Y.; Arioka, M.; Kitamoto, K. Vacuolar membrane dynamics in the filamentous fungus Aspergillus oryzae. Eukaryot. Cell 2006, 5, 411–442. [Google Scholar] [CrossRef]

Disclaimer/Publisher’s Note: The statements, opinions and data contained in all publications are solely those of the individual author(s) and contributor(s) and not of MDPI and/or the editor(s). MDPI and/or the editor(s) disclaim responsibility for any injury to people or property resulting from any ideas, methods, instructions or products referred to in the content. |
© 2024 by the authors. Licensee MDPI, Basel, Switzerland. This article is an open access article distributed under the terms and conditions of the Creative Commons Attribution (CC BY) license (https://creativecommons.org/licenses/by/4.0/).
Share and Cite
Liu, C.; Lei, L.; Zhu, J.; Chen, L.; Peng, S.; Zhang, M.; Zhang, Z.; Tang, J.; Chen, Q.; Kong, L.; et al. FgGET3, an ATPase of the GET Pathway, Is Important for the Development and Virulence of Fusarium graminearum. Int. J. Mol. Sci. 2024, 25, 12172. https://doi.org/10.3390/ijms252212172
Liu C, Lei L, Zhu J, Chen L, Peng S, Zhang M, Zhang Z, Tang J, Chen Q, Kong L, et al. FgGET3, an ATPase of the GET Pathway, Is Important for the Development and Virulence of Fusarium graminearum. International Journal of Molecular Sciences. 2024; 25(22):12172. https://doi.org/10.3390/ijms252212172
Chicago/Turabian StyleLiu, Caihong, Lu Lei, Jing Zhu, Lirun Chen, Shijing Peng, Mi Zhang, Ziyi Zhang, Jie Tang, Qing Chen, Li Kong, and et al. 2024. "FgGET3, an ATPase of the GET Pathway, Is Important for the Development and Virulence of Fusarium graminearum" International Journal of Molecular Sciences 25, no. 22: 12172. https://doi.org/10.3390/ijms252212172
APA StyleLiu, C., Lei, L., Zhu, J., Chen, L., Peng, S., Zhang, M., Zhang, Z., Tang, J., Chen, Q., Kong, L., Zheng, Y., Ladera-Carmona, M., Kogel, K.-H., Wei, Y., & Qi, P. (2024). FgGET3, an ATPase of the GET Pathway, Is Important for the Development and Virulence of Fusarium graminearum. International Journal of Molecular Sciences, 25(22), 12172. https://doi.org/10.3390/ijms252212172

